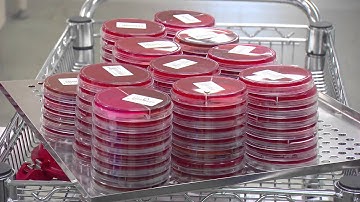
APAS -- Automated Plate Assessment System

⬇ DOWNLOAD NOW
Kalau muncul iklan pop-up, tutup lalu klik tombol kembali
Download lagu Introduction and use of an AI imaging device (APAS Independence) to autoverify Urine cultures secara gratis hanya untuk keperluan promosi. Dukung artis favorit kamu dengan membeli musik original di iTunes atau platform resmi lainnya.
 APAS Independence - Technology of APAS
APAS Independence - Technology of APAS
 APAS Independence Instrument from Clever Culture Systems
APAS Independence Instrument from Clever Culture Systems
 Automated EM Plate Reading for Pharma QC - APAS Independence
Automated EM Plate Reading for Pharma QC - APAS Independence
 Automate with Confidence - APAS Independence
Automate with Confidence - APAS Independence
 ECCMID Poster Insights - Introducing AI for early VRE culture reads with APAS ft. Manuel Morales
ECCMID Poster Insights - Introducing AI for early VRE culture reads with APAS ft. Manuel Morales
APAS -- Automated Plate Assessment System
APAS -- Automated Plate Assessment System
 ECCMID Poster Insights - AI-assisted antimicrobial susceptibility testing (AST) including Rapid-AST
ECCMID Poster Insights - AI-assisted antimicrobial susceptibility testing (AST) including Rapid-AST
 iLine F: A New Dimension In Automated Cell Culture Monitoring
iLine F: A New Dimension In Automated Cell Culture Monitoring